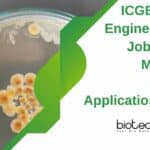
ICGEB JRF For MTech

Home Search
biology - search results
If you're not happy with the results, please do another search
Govt ILS BSc, MSc Life Sciences, Bioinformatics Project Job Openings, Apply Online
ILS Bioinformatics Job Opening - MSc, BSc Life Sciences Apply
ILS Bioinformatics Job Opening - MSc, BSc Life Sciences Apply. BSc, MSc, MTech Biotechnology, Life...
Biotech Research Associate Job Opening at UPL, Apply Online
Biotech Research Associate Job Opening at UPL, Apply Online
Biotech Research Associate Job Opening at UPL, Apply Online. PhD Biotech, Biochem and Microbiology Senior Research...
BBCI Walk-In-Interview For Scientific Assistant Post – MSc, MTech & BTech Eligible
BBCI Scientific Assistant Post - MSc, MTech & BTech Eligible
BBCI Scientific Assistant Post - MSc, MTech & BTech Eligible. Dr B Borooah Cancer Institute...
Genetics, Biotech & Microbio Candidates With 0-2 Years Exp Apply For JRF/PA Job at...
TERI Freshers Jobs MSc, MTech Biotech, Genetics, Microbiology Apply
TERI Freshers Jobs MSc, MTech Biotech, Genetics, Microbiology Apply. Interested and eligible candidates with MSc, MTech...
Biotecnika Times Newsletter 10.01.2023 Innovative Young Biotechnologist Fellowship, Merck Life Sciences Innovation Cup 2023
Biotecnika Times Newsletter 10.01.2023 Innovative Young Biotechnologist Fellowship, Merck Life Sciences Innovation Cup 2023
Har Gobind Khorana-Innovative Young Biotechnologist Fellowship 2022-23
Innovative Young Biotechnologist Fellowship 2022-23....
Top 10 CV Booster Tips To Get Jobs Faster | For Biotech & Life...
CV Writing Tips Freshers - Biotech & Life Sciences CV Writing
When it comes to finding a job in the biotech and life sciences industry,...
PhD Life Sciences Research Associate Job at ICGEB, Applications Invited
PhD Vacancy ICGEB Life Sciences - Applications Invited
PhD Vacancy ICGEB Life Sciences - Applications Invited. PhD Life Sciences Research Associate job at ICGEB. Interested...
National Institute of Animal Biotechnology Hiring For Project Associate Job
NIAB Project Opening Latest For MSc Candidates, Apply Online
NIAB Project Opening Latest For MSc Candidates, Apply Online. National Institute of Animal Biotechnology vacancies. MSc...
MAHE Manipal MSc Life Sciences Junior Research Fellow Recruitment
MAHE Manipal Research Vacancy For MSc Life Sciences
MAHE Manipal Research Vacancy For MSc Life Sciences. Manipal Academy of Higher Education (MAHE), Manipal MSc Life...
Merck KGaA Innovation Cup 2023 – Apply Now
Merck Innovation Cup 2023 - Apply Online
Merck Innovation Cup 2023 Germany - Life Science Candidates Apply. This is an interesting opportunity for life sciences...
Career Path & Scope After Bsc & Msc in Biochemistry
Scope of Biochemistry After BSc & MSc
A degree in Biochemistry can lead to a wide range of career opportunities in various fields. Biochemistry is...
Wildlife Institute of India Project Associate Job For Botany, Life Sciences
WII Project Vacancy Latest For MSc Botany, Life Sciences
WII Project Vacancy Latest For MSc Botany, Life Sciences. MSc Life Sciences, Botany job openings. Interested...
ICGEB Fungal Engineering JRF Job For MSc, MTech Life Sciences, Applications Invited
ICGEB JRF For MTech, MSc Life Sciences - Applications Invited
ICGEB JRF For MTech, MSc Life Sciences - Applications Invited. MSc and MTech Life Sciences...
ICAR-IARI Research Job Openings For Biotech, Biochem, Plant Sciences – Attend Walk-In
IARI Jobs For MSc - Biotech, Biochem, Mol Bio & Plant Sciences
IARI Jobs For MSc - Biotech, Biochem, Mol Bio & Plant Sciences. ICAR-IARI...
Govt ICFRE Project Jobs For BSc & MSc Botany, Life Sciences
Govt ICFRE Project Jobs For BSc & MSc Botany, Life Sciences
Govt ICFRE Project Jobs For BSc & MSc Botany, Life Sciences. BSc & MSc...